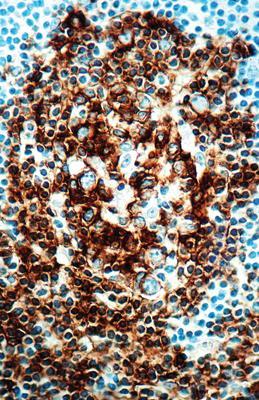

B Cell Cd20 Conc. Mab 1ml ,Each
$ 574.52
|
|
Details:
B Cell, CD20^ Clone number L26, This antibody is specific to a 33 kD polypeptide present on the majority of B cells in peripheral blood and lymphoid tissue and also with a minor component of 30 kD. No reactivity with other hematopoietic cells has been observed.
Additional Information
| SKU | 2320976 |
|---|---|
| UOM | EACH |
| UNSPSC | 12352203 |
| Manufacturer Part Number | MOB 004 |
| Product Dimensions | 8X5X4 Inches |
| Product Weight | 1 |

